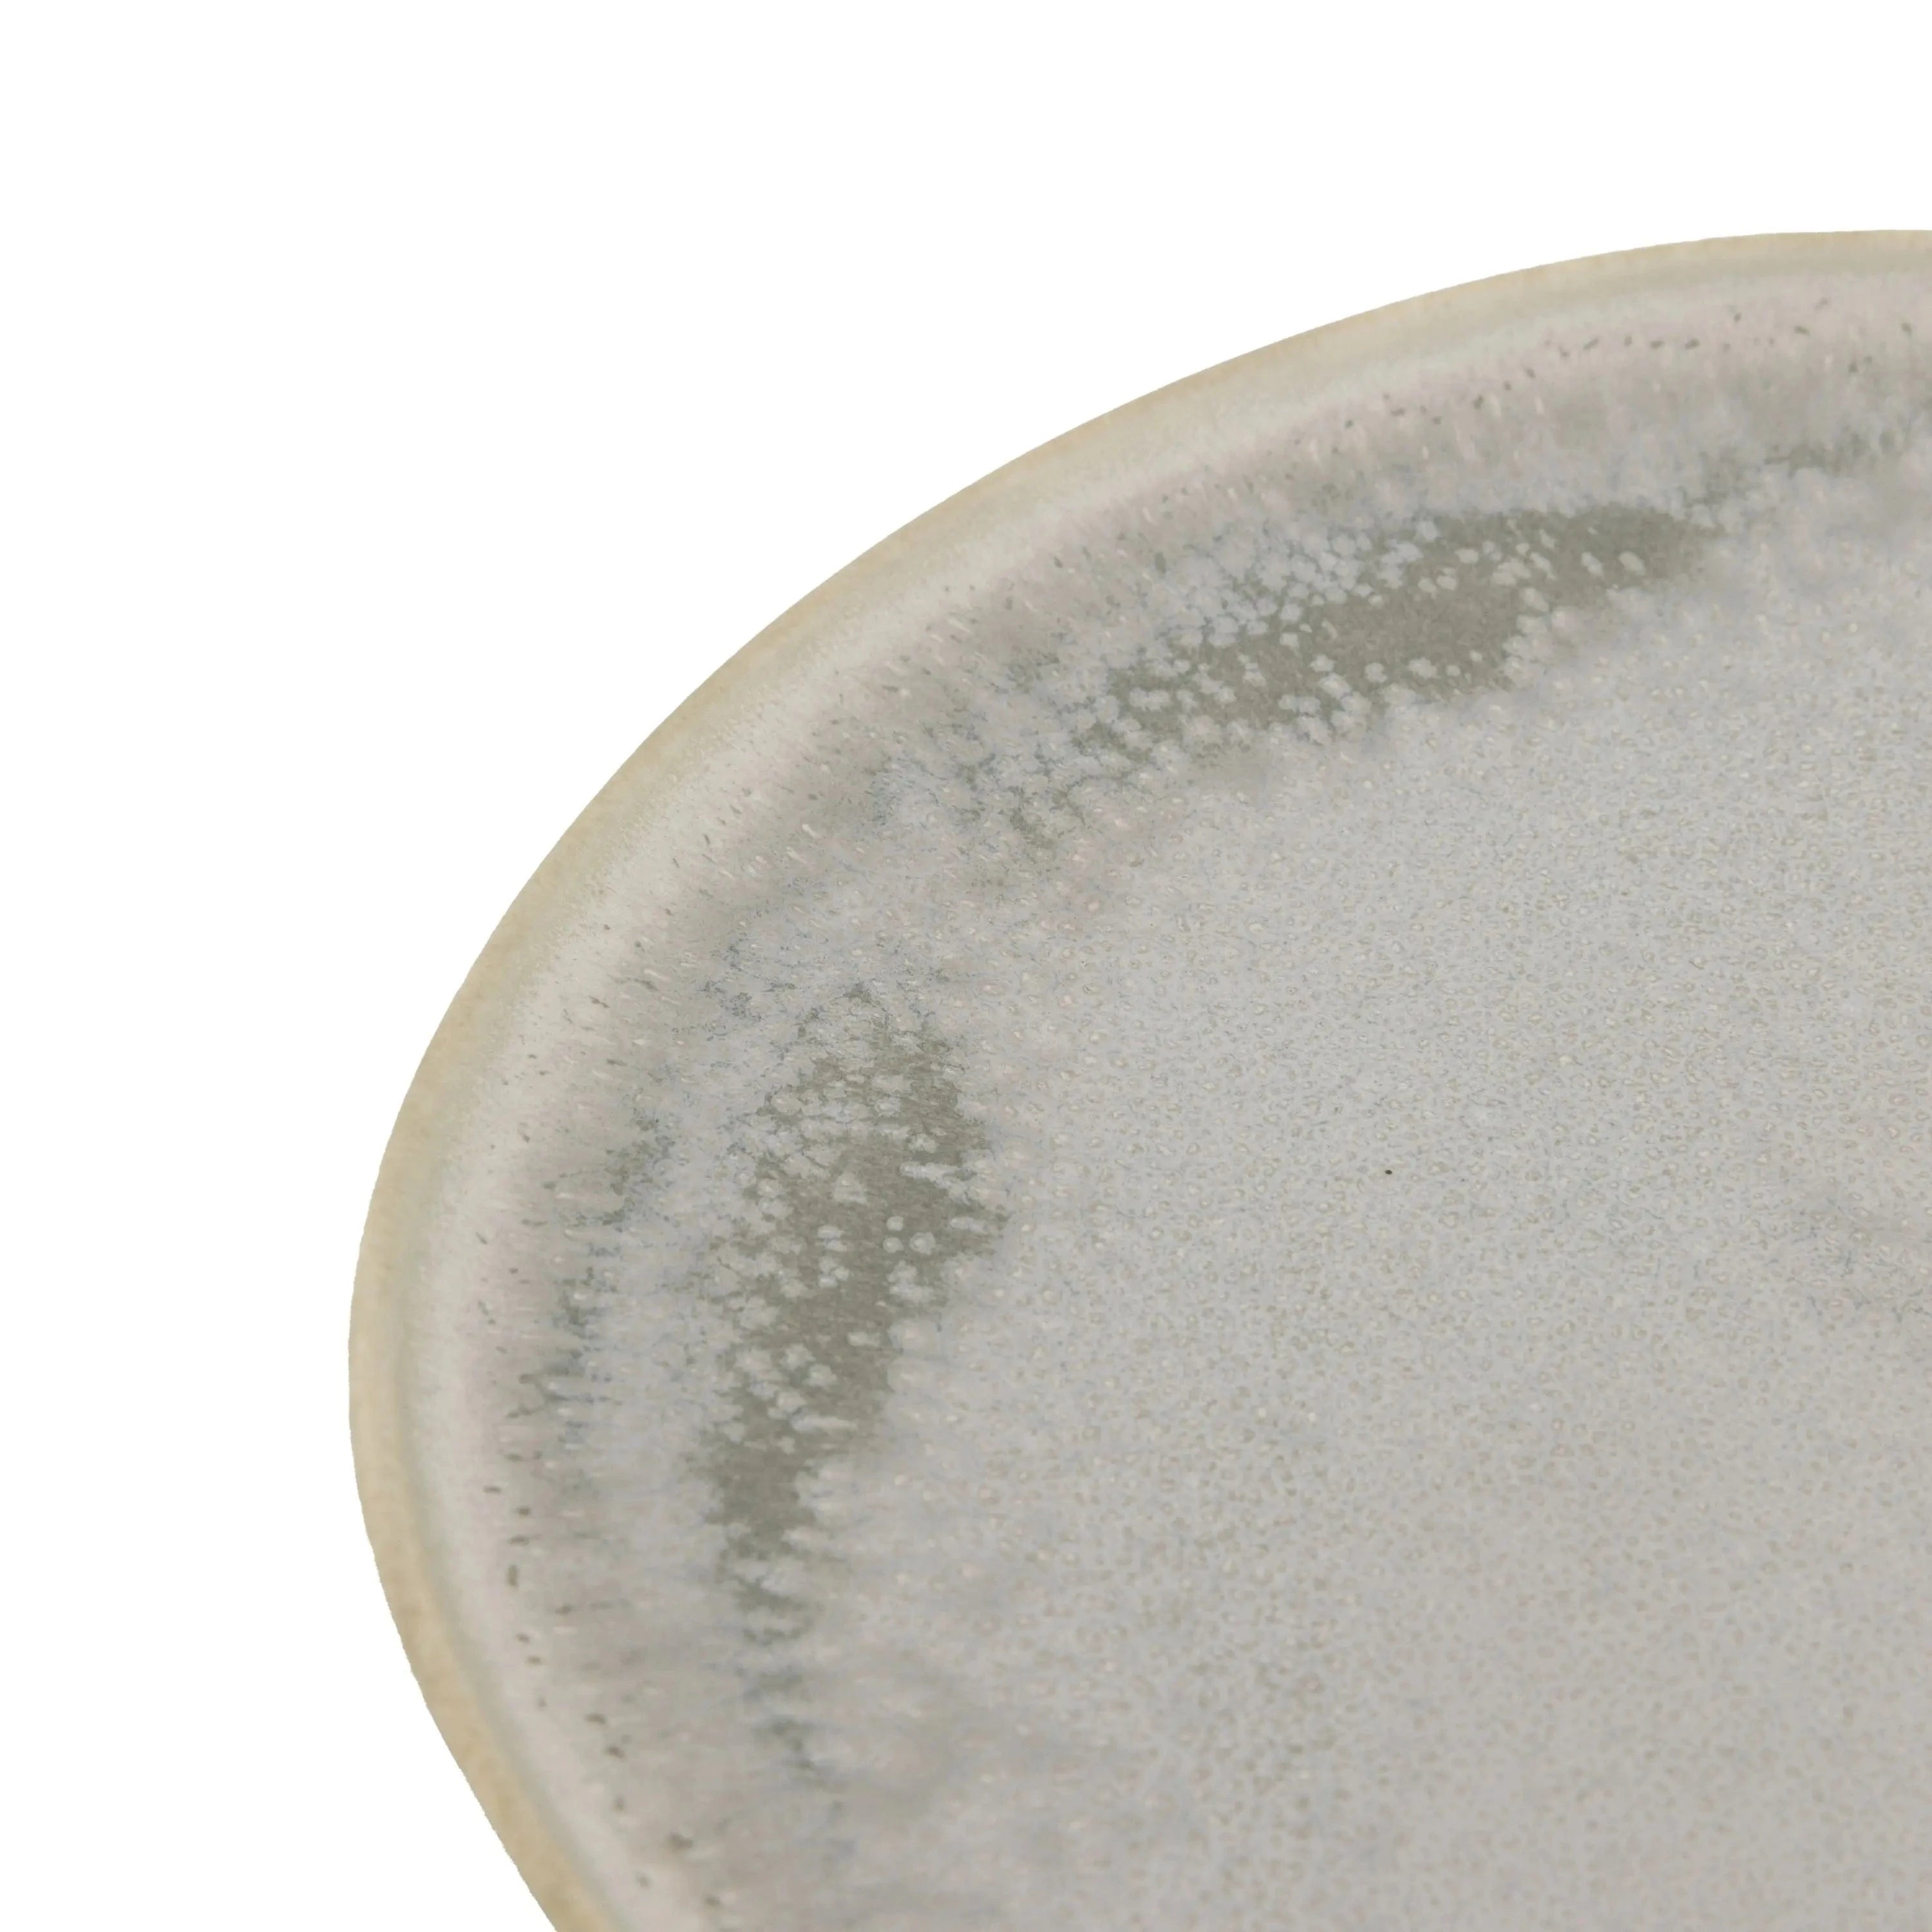

28 DAY RETURNS

Pebble Glaze Side Plate Dove Grey 4pk
Bodhi
Introducing the Pebble Glaze Side Plate Dove Grey 4pk, a clean and contemporary addition to your dinnerware collection. The organic forms of this set are beautifully complemented by its soft grey pebble-like glaze, creating a unique and stylish look for your table setting.
But what sets this product apart is its fast delivery. Made with a natural glaze style, each piece is fired in the kiln, resulting in slight variations that add to its one-of-a-kind charm. And with its dishwasher and microwave safe material, cleaning up after a meal has never been easier.
Details:
Colour: Stone
Material: Ceramic
Product Zone: Indoor
Additional Information: Dishwasher & Microwave Safe
Dimensions:
Item Width: 210 mm
Item Depth: 215 mm
Item Height: 25 mm
Packaged Length: 285 mm
Packaged Width: 285 mm
Packaged Height: 145 mm
Experience luxury and convenience with House of Isabella's Pebble Glaze Side Plate Dove Grey 4pk. Order now and enjoy free UK delivery on all our luxurious furniture and interiors.
STANDARD DELIVERY IS FREE FOR ALL OUR PRODUCTS!
Here at House of Isabella we do not believe in customers having to pay extra on top of their purchases for delivery. That's why we decided to take the bold step of offering all of our products with free standard delivery to UK Mainland addresses*. Please note delivery to Northern Ireland, Ireland, Scottish Highlands, Islands and Channel Islands are all not included within our free delivery service. Please contact us for a quotation.
Smaller Item Deliveries
Our smaller items are generally sent via conventional couriers such as Hermes, APC or DPD. Many offer a tracking service and an ETA of arrival given. We will of course share this information where applicable to your order. Please leave a contactable mobile phone number to ensure the couriers can contact you via call or text to arrange delivery where possible.
Larger Item Deliveries
For larger item deliveries, we use verified third party logistics companies who specialise in large, bulky item deliveries. We aim to have your products delivered to you within the time frame of between 4-10 working days.
At any one time, we can have anywhere up to 50,000 products on our website and although many items are in stock and available for immediate dispatch, we also place stock on backorder with our suppliers and manufacturers and many of which are available for pre-order.
Delays in this instance will be fully communicated and if you require a more specific time frame, please feel free to contact us before placing your order.
For larger, heavier items, customer assistance may be required to help the driver. Delivery is strictly to ground floor only for insurance purposes.
We ask that when receiving a delivery to check the items before the delivery driver leaves, to be able to return your delivery in the rare event of damage. If you do not manage to check goods upon delivery, we allow 24 hours after signing for goods for damages to be reported to us - claims for damages outside this period may be rejected.
Our delivery team will contact you to ask for a convenient date for delivery and in most cases the delivery can include a ETA time slot and informed by email or text message. Deliveries are generally only available during the working week Monday-Friday unless in special circumstances where arrangements can be made at additional cost for a weekend delivery. Please make sure you can be available to take delivery of your product or input an address for delivery where someone can be present i.e. a work address or relative/neighbour.
Please always inform us if you are going to be unavailable on the suggested delivery date, and we will endeavour to arrange a suitable alternative. Failed deliveries that have been agreed will result in re-delivery/cancellation charges. Late cancelled orders, where the item has been dispatched to the courier for delivery will incur a charge to redeliver the items back to us.
Once a delivery slot is confirmed by the customer, it is the customer's responsibility to ensure they will be available to receive the goods, otherwise a re-delivery charge will apply.
Please be aware it is the customer's responsibility to check that any orders will fit through doorways, stairwells and staircases. This includes any tables with tops in excess of 220cm. If you are in any doubt, please talk to our team prior to delivery who can advise. A re-delivery charge will need to be applied should our team need to return or use more specialist equipment than the standard two-man crew.
Due to the weight and size of some of our products, once the team arrive, it is the customer’s responsibility to move any pets and minors out of harms’ way during the installation for safety reasons.
Upon receipt of the goods, it is the customer’s responsibility to check over the order to ensure it is in good condition. We take full responsibility for any damage found during inspection only upon delivery.
Please note that all Outlet items are final sale and sold as seen. For this reason, they are not eligible for return.
If you have any questions about a product prior to purchase, we strongly recommend contacting a member of our team, who will be happy to provide further information and images where required.
This does not affect your statutory rights. If an item is faulty, damaged, or not as described, please contact us and we will be happy to assist.
 SECURE SHOPPING VIA CREDIT/DEBIT CARD
SECURE SHOPPING VIA CREDIT/DEBIT CARD
 INTERNATIONAL DESIGNER BRANDS
INTERNATIONAL DESIGNER BRANDS
 PRICE MATCH PROMISE - MORE INFO
PRICE MATCH PROMISE - MORE INFO
 International Delivery Quotable - MORE INFO
International Delivery Quotable - MORE INFO
You may also like
Recently viewed
Let customers speak for us
from 1705 reviewsI absolutely love this tree. It is larger in width that I expected & would have liked it to not have been as wide. However we have kept it & eventually I’ll buy a less wide olive tree for the position I have & will use this one in a larger space. It is beautiful & worth keeping.
The pot isn’t a pure white, which again I would have preferred. As you can see from the photos it looks good regardless of my preferences.
Loved it, i have ordered 2 more as one does not look right! But now it looks beautifully on the window still!
These chair are excellent. Very comfortable and look great. Leather is now even softer after using leather conditioner on them.
We are in love with our new coffee table, packaged with extreme care as to ensure no damage
A really sturdy and lovely looking garden set. Looks perfect in my garden. Very comfortable wihtout cushions too.
I have ordered one but its not enough soi have ordered again for another 2, lovely flowers!
Lovely well made well packed and lovely delivery people
Looked high and low for an adaptable dining table that would fit into a small space. It's really clever and neat the way I can extend the table if needed. Found HOI really efficient at both the ordering and arranging delivery. Would definitely use them again without any hesitation.
Lamp shades were well packed, safely delivered and reasonable price for the design.
Very happy with this sideboard. Lots of space and it looks great.
Extremely pleased with these beautiful pictures. Lovely colour palette. Good quality. Reminds me of places I've walked.
Absolutely gorgeous vase. The olive colour is beautiful to go with my olive stems. The vase is so light weight which is perfect.
It’s always nice and smooth sailing experience when shopping on your website
Beautiful piece of furniture, well made, was worth the wait
Perfect, love it
